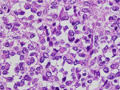

- 18.Soft tissue
- (6)Rhabdomyosarcoma
Microscopic findings (H.E. low power view): An irregularly-arranged proliferation of round to spindle-shaped small undifferentiated tumor cells admixed with tape- or racket-like or round tumor cells containing abundant eosinophilic cytoplasms. Cytoplasmic cross striations are occasionally identified. Massive intratumoral necrosis frequently detected.
Click the image to see the enlarged image.